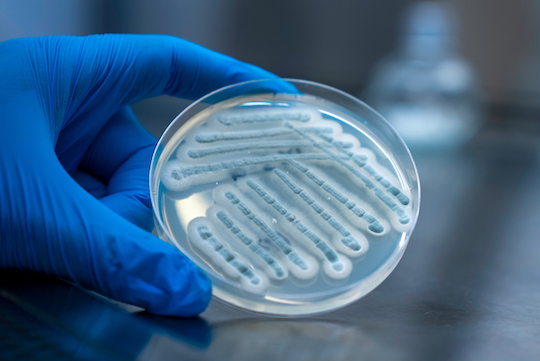

New Enzyme Could Aid Anticancer Drug Development
Rice U. study provides complete roadmap to complex molecule assembly
Many of the drugs we use to treat cancer and infectious disease are ⎯ or derive from ⎯ natural products, but it’s difficult to know exactly how nature assembles them.
 Qiuyue Nie (left) and Shuai Liu. (Photo by Gustavo Raskosky/Rice University)
Qiuyue Nie (left) and Shuai Liu. (Photo by Gustavo Raskosky/Rice University)
Retracing nature’s steps, Rice University chemical engineer Xue Gao and her team mapped out the full series of enzyme-powered reactions a marine fungus uses to produce 21R-citrinadin A, a complex molecule with anticancer properties.
In the process, Gao and her collaborators identified a new enzyme, CtdY, which is the only one of its kind known to break an amide bond, according to the study published in the Journal of the American Chemical Society.
“CtdY belongs to a large family of enzymes known as cytochrome P450s that perform a variety of different functions and are being studied for their potential use in industrial and pharmaceutical settings,” Gao said. “However, none of the P450s documented so far can break an amide bond.
“Amide bonds are found in all proteins ⎯ they’re the ones linking the amino acids together. It’s a fundamental, very stable type of bond.”
The enzyme’s ability to cleave amide bonds could make it a useful tool for creating new drugs.
“The fact that CtdY can do this is quite remarkable,” said Qiuyue Nie, a postdoctoral researcher in the Gao lab who is one of the lead authors of the study. “It holds significant promise for the pharmaceutical industry,” she said.
The enzyme is notable not only because it can break a highly-stable bond, but also because it does so for a very complex molecular structure.
“You want to maintain the rest of this structure and only want to break this single, hard-to-break bond ⎯ this is a very specific and difficult task,” Gao said.
Over twenty enzymes are involved in the production of the 21R-citrinadin A molecule. (Photo by Gustavo Raskosky/Rice University)
Over twenty enzymes are involved in the production of the 21R-citrinadin A molecule. (Photo by Gustavo Raskosky/Rice University)
Once CtdY breaks the amide bond ⎯ which has a circular 3D structure ⎯ a group of seven other enzymes intervene to complete the assembly of the 21R-citrinadin A molecule.
“Once it opens the ring, all the other enzymes are able to perform oxidation and install oxygen-hydrogen groups in a highly precise way,” Gao said. “It’s like CtdY brings the Christmas tree home, and then these other enzymes come together to decorate it.”
The Gao lab has been working for years to uncover all the steps involved in the production of the 21R-citrinadin A compound, which has been shown to be effective against leukemia in rats and human throat cancer cells, according to Shuai Liu, a Rice postdoctoral researcher who is the study’s lead co-author.
The newly identified enzyme is one of several discovered by the Gao lab that can perform singular catalytic functions such as controlling chirality and facilitating the Diels-Alder reaction.
“This really is a complete story,” Gao said. “We used gene knockout, heterologous expression, mutagenesis studies, enzymology and so on to solve nearly every single step in the biosynthesis of this compound. Over 20 enzymes assemble and coordinate to produce the molecule. I find it fascinating that enzymes work cooperatively in this way to produce this wonderfully complex molecule.”
Gao is Rice’s T.N. Law Assistant Professor of Chemical and Biomolecular Engineering and an assistant professor of bioengineering and chemistry.
The National Institutes of Health (R35GM138207) and the Robert A. Welch Foundation (C-1952) supported the research
Publication: Atanas G. Atanasov, et al., Natural products in drug discovery: advances and opportunities, Nature Reviews (2023). DOI: 10.1038/s41573-020-00114-z
Original Story Source: Rice University

 Alerts Sign-up
Alerts Sign-up